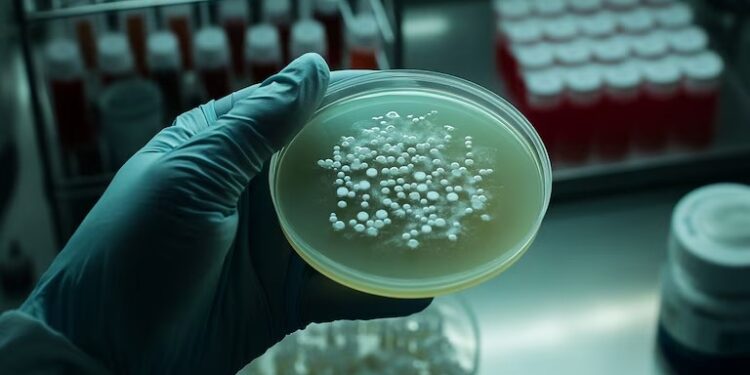

Afecta a dos edificios que comparten un tanque con agua de pozo y sospechan que la contaminación del suministro fue el origen del foco infeccioso. Cuáles son los síntomas
El número de contagios confirmados porLas pruebas fueron realizadas por el laboratorio de ANLIS/Malbrán, que validó la presencia de la bacteriaSalmonella Typhi en las muestras de los pacientes afectados.
¿Dónde comenzó el brote de fiebre tifoidea?
El foco infeccioso se localiza en dos construcciones de la calle San Ignacio al 700, donde unas 70 familias comparten un sistema de provisión de agua de pozo, almacenada en tanques sin supervisión sanitaria.
Las autoridades sanitarias provinciales y municipales señalaron que el origen más probable del contagio fue la contaminación bacteriana del sistema de agua, aunque se siguen esperando resultados definitivos del análisis químico y bacteriológico.
Hasta el momento, una mujer falleció luego de haber estado internada, aunque la causa de muerte aún no fue confirmada oficialmente como derivada de la enfermedad.
La mayoría de los casos confirmados se concentran entre los 6 y los 53 años, con una mediana de edad de 22. Al menos seis personas fueron hospitalizadas y dos requirieron cuidados intensivos.
¿Qué es la fiebre tifoidea?

La fiebre tifoidea es una enfermedad infecciosa sistémica provocada por la bacteria Salmonella Typhi, que afecta al intestino y se disemina a través del torrente sanguíneo.
En diálogo con Infobae, el médico infectólogo Ricardo Teijeiro explicó que “la salmonela es una bacteria intestinal que habitualmente se transmite de humano a humano, a través de la materia fecal. La fiebre tifoidea es causada por una cepa específica, la Salmonella Typhi, que puede infectar por cualquier vía contaminada: alimentos, agua potable o las manos”.
“Esa bacteria circulando por sangre puede impactar en cualquier órgano noble —corazón, riñón, hígado, cerebro— y generar complicaciones graves que pueden incluso derivar en la muerte”, advirtió Teijeiro.
La bacteria se propaga por medio del consumo de alimentos o agua contaminados con materia fecal y se encuentra más frecuentemente en zonas donde hay deficiencias en el acceso al agua potable y al saneamiento básico.
¿Cuáles son los síntomas de la fiebre tifoidea?

La Sociedad Argentina de Infectología (Sadi) enumeró los síntomas principales de la fiebre tifoidea:
- Fiebre elevada y persistente
- Dolor abdominal
- Malestar general, debilidad
- Náuseas y vómitos
- Diarrea o constipación
- Cefalea
- En algunos casos, manchas rosadas en pecho y abdomen
En los cuadros graves, si no se trata a tiempo, la infección puede derivar en perforaciones intestinales, hemorragias internas o infecciones generalizadas.
¿Cuándo acudir al médico por los síntomas?

Teijeiro remarcó la importancia del diagnóstico temprano: “Con el antibiótico adecuado, la enfermedad evoluciona muy bien. Pero hay que consultar al médico apenas aparecen los primeros síntomas, especialmente en el caso de los niños pequeños, que son los más vulnerables a desarrollar complicaciones”.
Se recomienda acudir de inmediato si se presentan:
- Fiebre alta durante más de tres días
- Dolor abdominal constante
- Diarrea prolongada
- Vómitos, náuseas o decaimiento general
El diagnóstico se confirma mediante análisis bacteriológicos, como cultivos de sangre o materia fecal.
¿Cómo prevenir la fiebre tifoidea?

Las principales estrategias de prevención son:
- Consumir agua segura, ya sea embotellada o de red verificada
- Hervir el agua solo si es segura químicamente, ya que hervir agua contaminada con nitratos la vuelve aún más peligrosa
- Lavarse las manos frecuentemente con agua y jabón, especialmente después de ir al baño y antes de cocinar o comer
- Lavar frutas y verduras con agua segura, especialmente si se consumen crudas
- Evitar alimentos crudos o mal cocidos, como huevos, carne o pescado
- Desechar adecuadamente los pañales descartables
Las autoridades sanitarias de Tres de Febrero y la provincia de Buenos Aires entregaron kits de desinfección y continúan realizando operativos de provisión de agua potable mediante camiones cisterna, mientras se avanza en la reconexión formal a la red de AYSA.
¿Cuál es el tratamiento para la fiebre tifoidea?

El tratamiento consiste en la administración de antibióticos específicos para eliminar la bacteria. “Tiene tratamiento, tiene indicación de antibiótico y con eso se evitan las complicaciones”, afirmó Teijeiro. El éxito del tratamiento depende en gran parte de la rapidez con la que se realiza el diagnóstico y del acceso a la medicación adecuada.
Con atención médica oportuna, la letalidad de la enfermedad se reduce a menos del 1%. Sin tratamiento, puede alcanzar hasta un 30%, especialmente en pacientes inmunocomprometidos o en contextos de salud precaria.
Por Valeria Chavez – Infobae